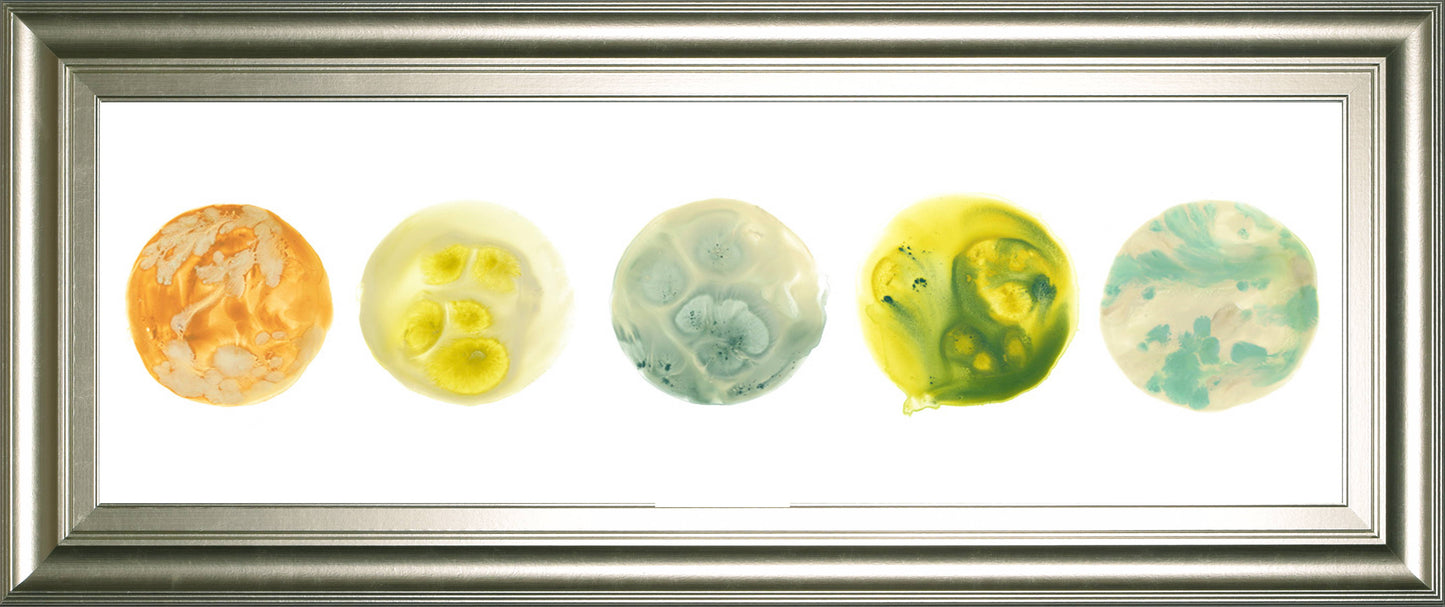

1
/
of
4
Planetary VIII By June Erica Vess - Framed Print Wall Art - Yellow
Vendor:
Classy Art
SKU
1916
Original
$69.99
Original
$89.99
Sale price
$69.99
Unit price
/
per
Shipping & Returns
Shipping & Returns
There are no refunds on delayed deliveries. Please call store for availability BEFORE checking out: 773-253-4666
Please call store for availability BEFORE checking out: 773-253-4666
Couldn't load pickup availability
Every planet has its unique craters and colors. Add this piece to your home decor and pair with its sister piece "Planetary VIl" for an instant uplift.
Product Features
Planetary VIII By June Erica Vess - Framed Print Wall Art - Yellow
42.0"W x 1.0"D x 18.0"H - 10.0 lb
Product Features
- Every planet has its unique craters and colors. Add this piece to your home decor and pair with its sister piece "Planetary VIl" for an instant uplift.
- Wide 3 inch frame
- Real glass
- Ready to hang
- Made in the USA
- Framed In Silver Serenity
- Astronomy & Space
- Abstract Shapes
- Horizontal
- June Erica Vess
- Wipe clean with damp cloth
Planetary VIII By June Erica Vess - Framed Print Wall Art - Yellow
42.0"W x 1.0"D x 18.0"H - 10.0 lb

View in Room
Scan this QR code with your mobile device's camera to view this product in AR in your room
You may also like
-
SimpleJoy - Oversized Accent Ottoman
Original $269.99OriginalUnit price / per$319.99Sale price $269.99Sale -
Savonport - Five Drawer Chest - White / Brown
Original $419.99OriginalUnit price / per$499.99Sale price $419.99Sale -
Savonport - Two Drawer Night Stand - White / Brown
Original $209.99OriginalUnit price / per$249.99Sale price $209.99Sale -
 Sale
SaleElyza - Sectional
Original $6,119.90OriginalUnit price / per$7,329.90Sale price $6,119.90Sale -
 Sale
SaleMaggie - Loveseat
Original $849.99OriginalUnit price / per$1,009.99Sale price $849.99Sale -
Maggie - Chair And A Half
Original $749.99OriginalUnit price / per$899.99Sale price $749.99Sale -
 Sale
SaleMaggie - Ottoman
Original $329.99OriginalUnit price / per$389.99Sale price $329.99Sale -
Aprilyn - Bookcase Headboard
Original $169.99OriginalUnit price / per$199.99Sale price $169.99Sale -
Langdrew - Cube Organizer
Original $99.99OriginalUnit price / per$119.99Sale price $99.99Sale -
Elyza - Oversized Ottoman
Original $519.99OriginalUnit price / per$619.99Sale price $519.99Sale -
 Sale
SaleWaylowe - Bar Cart
Original $189.99OriginalUnit price / per$229.99Sale price $189.99Sale -
 Sale
SaleMaggie - Sofa
Original $929.99OriginalUnit price / per$1,109.99Sale price $929.99Sale -
Weekender - 10" Gel Memory Foam Mattress
Original From $329.99OriginalUnit price / per$389.99Sale price From $329.99Sale -
Weekender - 8" Gel Memory Foam Mattress
Original From $289.99OriginalUnit price / per$339.99Sale price From $289.99Sale -
Weekender - 6" Gel Memory Foam Mattress With Waterproof Cover - Twin
Original $229.99OriginalUnit price / per$269.99Sale price $229.99Sale -
Shoulder Zoned - Gel ActiveDough Bed Pillow
Original From $79.99OriginalUnit price / per$89.99Sale price From $79.99Sale -
Brushed Microfiber - Short Queen Bed Sheet - White
Original $49.99OriginalUnit price / per$59.99Sale price $49.99Sold out -
Ticanter - Dresser - Brown
Original $829.99OriginalUnit price / per$989.99Sale price $829.99Sale -
Ticanter - Five Drawer Chest - Brown
Original $789.99OriginalUnit price / per$949.99Sale price $789.99Sale -
Ticanter - Three Drawer Night Stand - Brown
Original $349.99OriginalUnit price / per$419.99Sale price $349.99Sale -
Weekender - 2" Memory Foam Mattress Topper
Original From $59.99OriginalUnit price / per$69.99Sale price From $59.99Sale -
Gramburg - Six Drawer Dresser
Original From $479.99OriginalUnit price / per$579.99Sale price From $479.99Sale -
Fannin - 4-Piece Sectional With Ottoman - Ivory
Original $1,159.98OriginalUnit price / per$1,389.98Sale price $1,159.98Sale -
Marxmore - Upholstered Storage Bed
Original From $1,069.97OriginalUnit price / per$1,279.97Sale price From $1,069.97Sale -
 Sale
SaleMarxmore - Dresser
Original From $1,099.99OriginalUnit price / per$1,319.99Sale price From $1,099.99Sale -
Carceri - Reclining Sectional
Original From $1,819.98OriginalUnit price / per$2,179.98Sale price From $1,819.98Sale -
Gravier - Reclining Sectional
Original From $4,159.95OriginalUnit price / per$4,999.95Sale price From $4,159.95Sale -
Pearce-Pike - Reclining Sectional
Original $2,019.97OriginalUnit price / per$2,419.97Sale price $2,019.97Sale -
 Sale
SaleLentiz - Sectional
Original $1,339.98OriginalUnit price / per$1,599.98Sale price $1,339.98Sale -
Maxton Heights - Sectional
Original From $2,509.96OriginalUnit price / per$2,999.96Sale price From $2,509.96Sale -
Karallin - Panel Storage Bed
Original From $1,239.97OriginalUnit price / per$1,489.97Sale price From $1,239.97Sale -
 Sale
SaleKarallin - Panel Bed
Original From $879.97OriginalUnit price / per$1,059.97Sale price From $879.97Sale -
Wittenmyer - TV Stand
Original From $989.99OriginalUnit price / per$1,179.99Sale price From $989.99Sale -
Max-Momentum - Reclining Sectional
Original From $2,499.95OriginalUnit price / per$2,999.95Sale price From $2,499.95Sale -
Lakepoint - Sectional
Original $1,579.98OriginalUnit price / per$1,879.98Sale price $1,579.98Sale -
Mixed Motion - Power Reclining Loveseat With Console / Adjustable Headrest
Original $1,429.99OriginalUnit price / per$1,709.99Sale price $1,429.99Sale -
Mixed Motion - Power Reclining Sofa With Adjustable Headrest
Original $1,469.99OriginalUnit price / per$1,759.99Sale price $1,469.99Sale -
Mixed Motion - Power Recliner With Adjustable Headrest
Original $909.99OriginalUnit price / per$1,089.99Sale price $909.99Sale -
Glennbre - Ottoman - Midnight
Original $249.99OriginalUnit price / per$299.99Sale price $249.99Sale -
Glennbre - Loveseat - Midnight
Original $549.99OriginalUnit price / per$659.99Sale price $549.99Sale -
Elevate Edges - Glide Reclining Loveseat With Console - Coin
Original $1,319.99OriginalUnit price / per$1,589.99Sale price $1,319.99Sale -
Gruaro - Power Reclining Loveseat With Console / Adjustable Headrest - Amber
Original $1,939.99OriginalUnit price / per$2,329.99Sale price $1,939.99Sale -
Gramburg - Five Drawer Chest - Warm Natural Brown
Original $459.99OriginalUnit price / per$549.99Sale price $459.99Sale -
Gramburg - Bedroom Mirror - Warm Natural Brown
Original $99.99OriginalUnit price / per$109.99Sale price $99.99Sale -
Gramburg - Two Drawer Night Stand - Warm Natural Brown
Original $229.99OriginalUnit price / per$279.99Sale price $229.99Sale -
Lentiz - Oversized Accent Ottoman - Onyx
Original $329.99OriginalUnit price / per$399.99Sale price $329.99Sale -
Glennbre - Sofa - Midnight
Original $619.99OriginalUnit price / per$749.99Sale price $619.99Sale -
Elevate Edges - Glider Recliner - Coin
Original $769.99OriginalUnit price / per$919.99Sale price $769.99Sale






























































